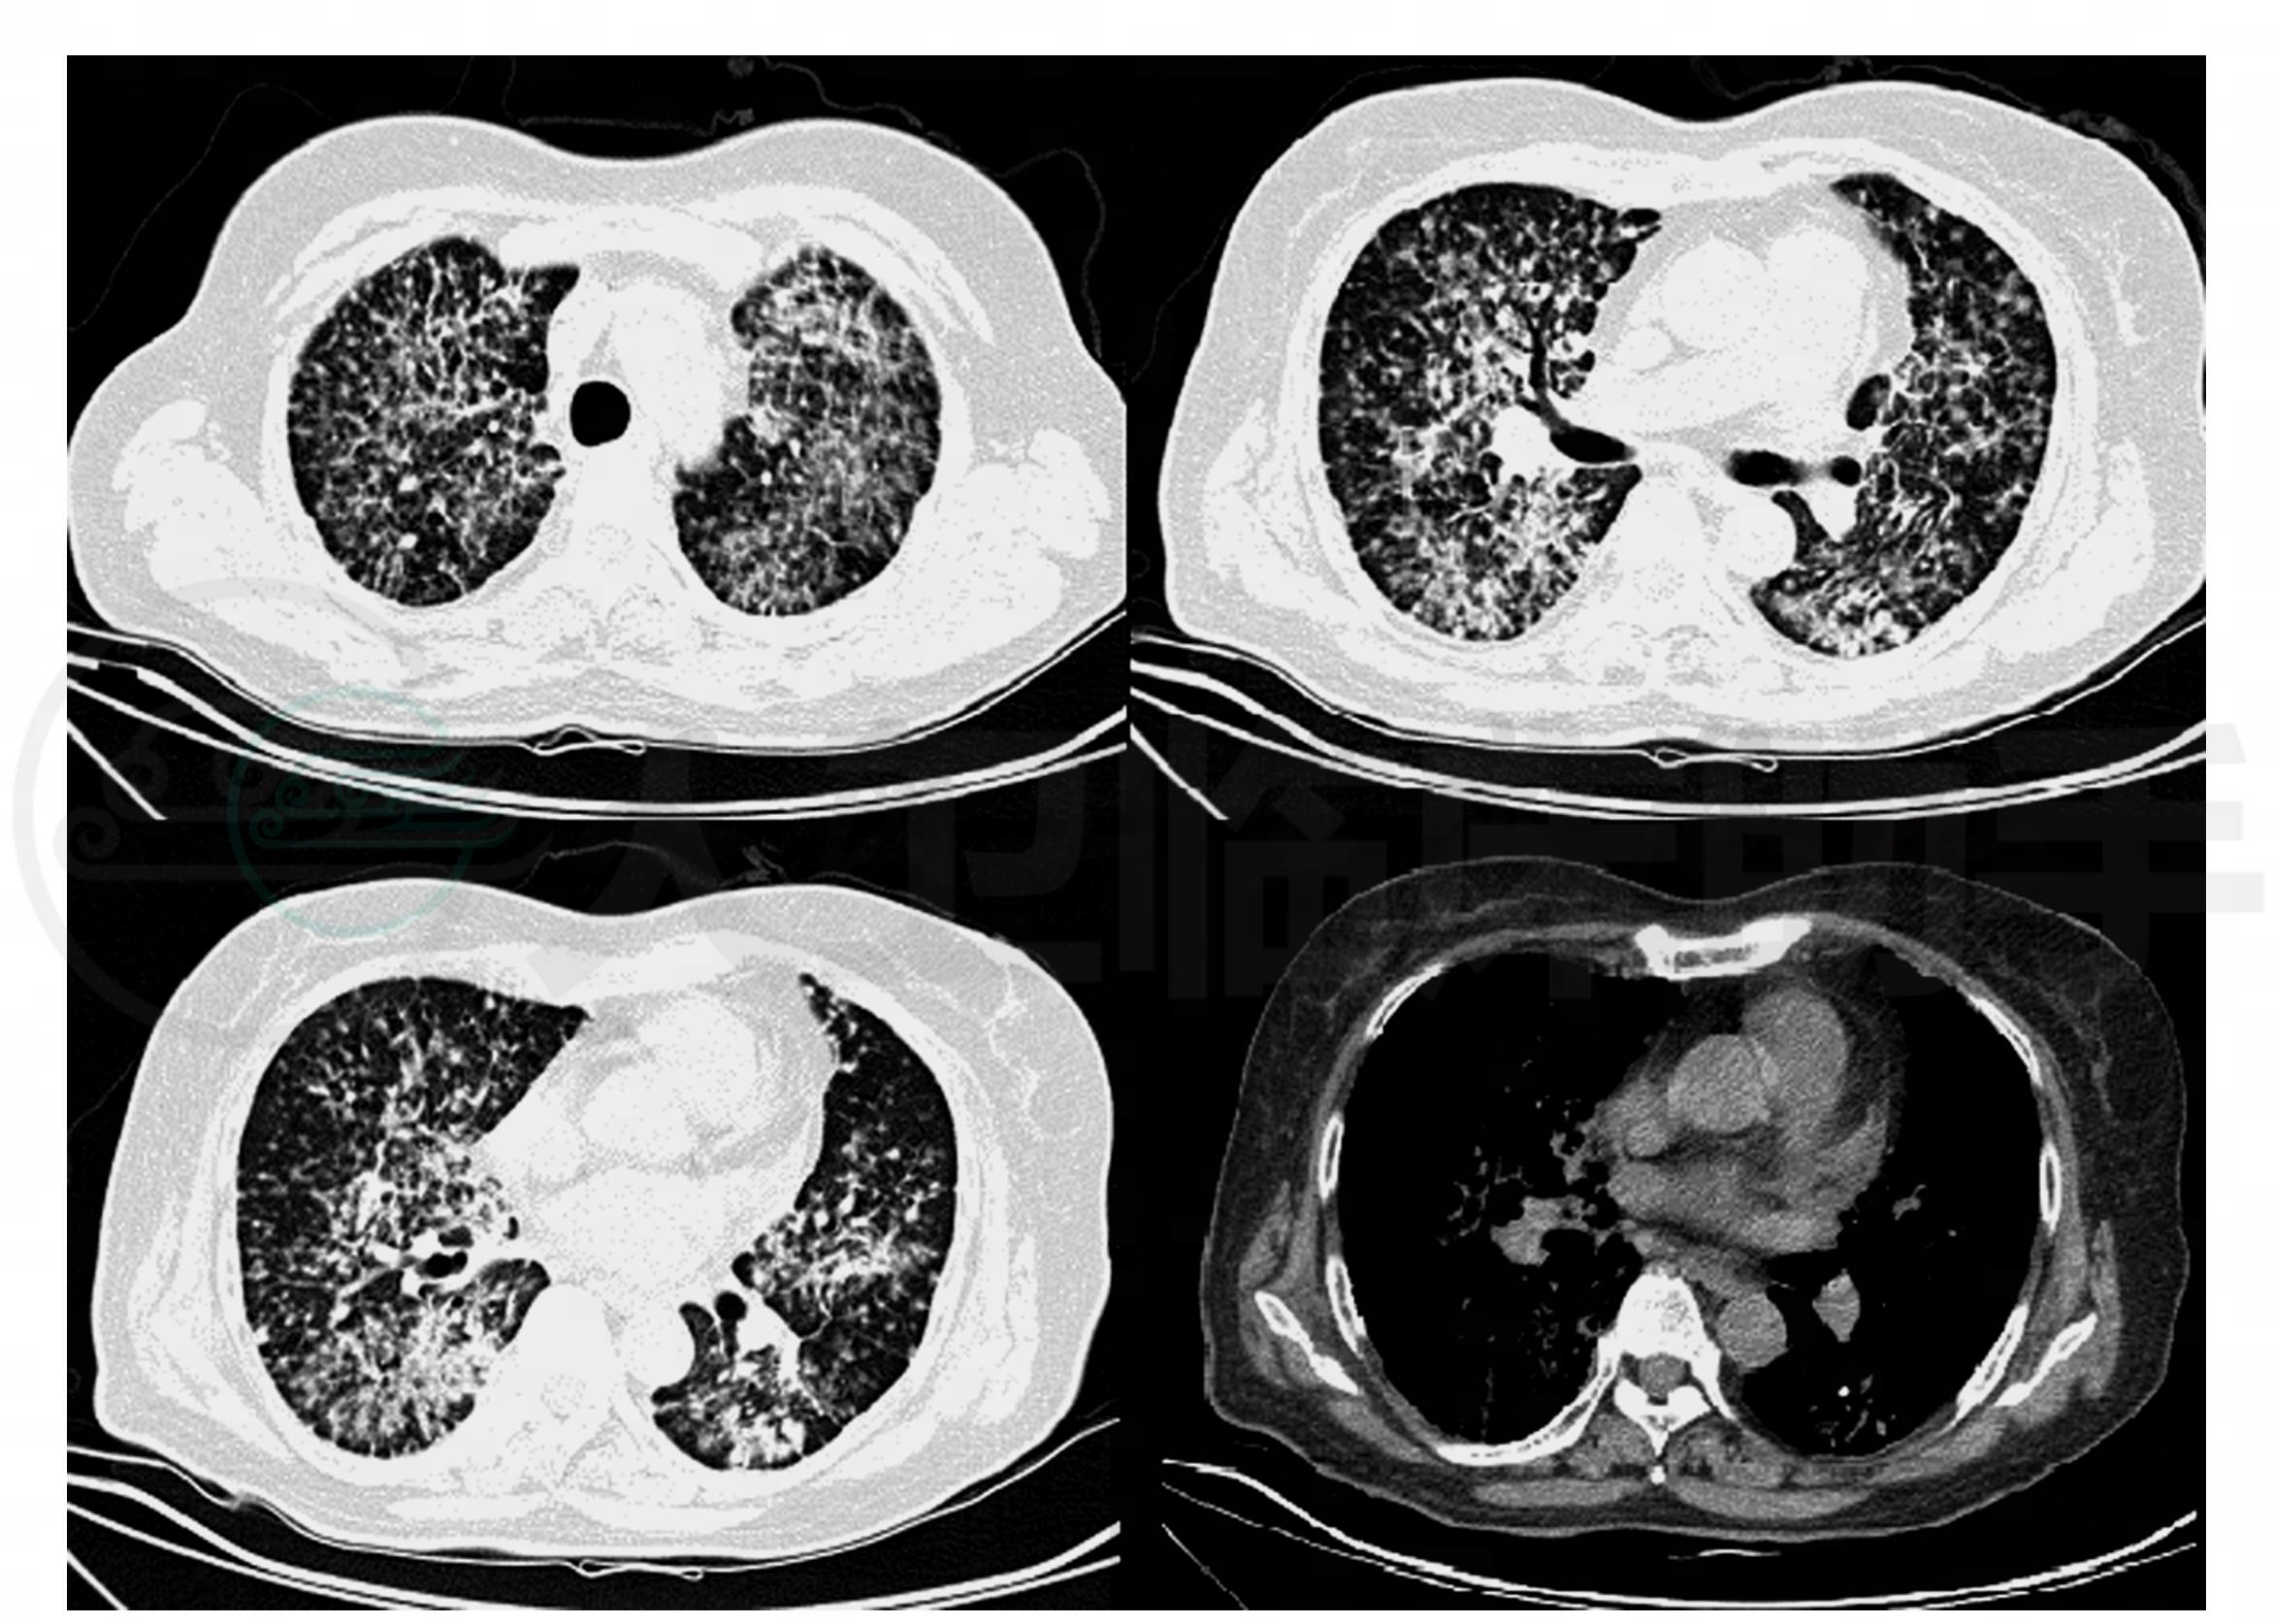

细支气管肺泡细胞癌(bronchioloalveolar cell carcinoma,BAC)是腺癌的一种类型,起源于细支气管黏膜上皮或肺泡上皮,又称为细支气管肺泡癌,简称肺泡癌。目前本病的发病率呈逐年上升趋势,随着研究的深入,发现BAC在病理、影像学表现、诊断标准、治疗、预后等方面不同于一般腺癌,引起广泛关注,已成为国内外肺癌领域研究的热点。本病的临床症状多种多样,因缺乏特异性,易导致误诊和漏诊,因此我们认为应提高对该疾病的认识。
女患,67岁,以“胸闷气短2个月”为主诉入院。
患者2个月来反复出现活动后胸闷气短,伴有乏力,无发热,无盗汗,无咳嗽咳痰,无咯血及痰中带血,无胸痛。患者病来有恶心,偶有呕吐胃内容物,无腹痛腹泻,无尿急尿频尿痛,无关节痛,饮食可,二便正常,体重较前减轻十余斤。既往史:7年前患脑梗死及高血压,目前服用波依定及卡托普利控制血压,未监测血压。否认糖尿病病史,否认肝炎、结核等传染病病史,无外伤史。无有机粉尘接触史,无饲鸽史。
入院时查体:T 36.3℃,HR 77次/分,BP 120/ 80mmHg,R 20次/分,神清语明,查体合作,步入病房,周身皮肤无皮疹,周身皮肤黏膜无黄染及出血点,右侧大腿外侧可见一直径为3cm的肿物,质软,无触痛,位置固定,浅表淋巴结未触及肿大,睑结膜无苍白,巩膜无黄染,口唇发绀,口腔黏膜未见疱疹,咽不赤,扁桃体不大,颈软,颈静脉轻度充盈,颈静脉无怒张,气管居中,双肺听诊呼吸音清,未闻及明显干湿啰音,心音有力,律齐,各瓣膜听诊区未闻及病理性杂音,腹软,全腹无压痛、反跳痛及肌紧张,肝脾肋下未触及,肝肾区无叩痛,双下肢无水肿。
入院时辅助检查:血常规:WBC 16.5×109/L,NE%69.2%,HB 138g/L,PLT 282×109/L;肺CT:双肺弥漫分布大小不等结节影,部分结节影呈磨玻璃密度,部分呈“树芽”征,部分结节密度较致密,部分结节融合,结节分布不均,小叶间隔增厚,左肺下实变影内见钙化,肺内多发钙化结节,纵隔见多组钙化小淋巴结(图1)。
图1 双肺弥漫分布大小不等结节影,部分结节影呈磨玻璃密度,部分呈“树芽”征,部分结节密度较致密,部分结节融合,结节分布不均;小叶间隔增厚,左肺下实变影内见钙化
入院诊断:双肺弥漫结节性病变性质待定
诊治经过及疾病演变:入院后给予抗炎对症治疗。实验室检查回报:血气分析:pH 7.44,PaCO2 37.4mmHg,PaO2 70.9mmHg,SaO2 94.9%;ALB 32.20g/L,ALT 12U/L,AST 9U/L,总胆红素23.8μmol/L,直接胆红素8.0μmol/L,间接胆红素15.8μmol/L;结核抗体:阴性;血清肿瘤标记物:癌胚抗原11.04ng/ml,神经原特异烯醇酶13.11ng/ml,细胞角蛋白19片段7.79ng/ml;支气管镜可见:右肺支气管分支变异;支气管肺泡灌洗液细胞学检查:分叶核细胞15.0%,淋巴细胞11.0%,杆状核细胞1.0%,巨噬细胞73.0%;结核菌培养(噬菌体法):阴性;PPD 72小时结果为弱阳性;肺功能:限制性肺通气功能障碍,小气管功能重度减退,弥散功能低下;胃镜检查:食管炎,红斑/渗出性胃炎,胃息肉;全身PET/CT扫描,未见异常代谢病灶。入院第7天支气管肺泡灌洗液病理检查回报:找到瘤细胞,腺癌可能性大(图2)。患者接受化疗,出院。
出院诊断:肺癌(肺泡细胞癌可能性大)

图2 细胞核大,圆形,深染,有少量胞浆。腺癌可能性大













